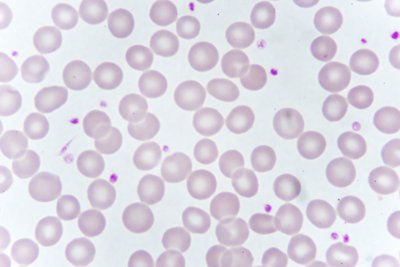

Our Long-term Vision and Pioneering Attitude
The pharmaceutical industry is undergoing major changes, challenging the way manufacturers approach the safety and quality of treatments for patients. Our ambition is to be recognized as the partner of choice for smart quality control of manufacturers around the globe, targeting both patient safety and customer productivity.
What has set us apart as a trusted reference for worldwide leaders in the pharmaceutical sector for over 60 years?
- Our passionate team members, who are present in more than 100 countries
- Our unrivaled investment in innovation
- The rigorous science behind our quality control promise
Our Commitment to Our Customers
- Expertise
- Applications
- Solutions
Specialty
Application
Products
Products
-
3P® CONNECT
EM-body Connectivity
3P® CONNECT is designed to secure sample traceability and collection of your Environmental Monitoring (EM) data to ensure reliable decision-making and optimize process efficiency. This comprehensive system includes dedicated software and performant pre-barcoded 3P® SMART PLATES. Skipping the traditional paper-based process for EM decreases risk of errors and saves time during the entire production process.
-
3P® ENTERPRISE
EM-Power the Future
Bridging the gap between standard processes and automation, 3P® ENTERPRISE transforms the future of environmental monitoring in the pharmaceutical industry. From sampling to trending, take control with an end-to-end, fully digitalized and automated workflow. Increase efficiency and ensure your products are safe and compliant with an innovative environmental monitoring system
-
3P® SMART PLATES
EM-brace Traceability
When conducting routine microbial surveillance of pharmaceutical manufacturing facilities, accuracy can empower you to make smarter decisions, meaning products, employees, and patients remain safe, and your business operates in compliance with regulatory guidelines. When it comes to Environmental Monitoring (EM), state-of-the-art culture media is a necessity when you’re counting on traceability and definitive results.
-
3P® Support & Services
Your Vision, Our Mission
As your partner, we’re committed to providing you with the assistance and services you need to make implementation easier and faster.
-
ACCELLIX
Bringing the power of flow cytometry to GMP manufacturing.
Cell and Gene Therapy Quality Control is critical. It doesn’t have to be difficult.
Stringent process controls are needed to monitor critical parameters throughout the cell therapy manufacturing process, and these laborious tests are challenging to scale. The Accellix Automated Cell Phenotyping Platform eliminates these limitations and automates your entire QC workflow from sample preparation to data analysis, generating rapid cell phenotyping results directly in the manufacturing suite.get in
-
AIR IDEAL® 3P®
Bring Confidence to your Environmental Monitoring
AIR IDEAL® 3P® is used for the detection of viable organisms through active air sampling.
-
API®
Manual Microbial Identification
API® makes microbial identification simple and reliable. Combining a standardized method with an extensive and robust digital microbial ID knowledge base, API® can easily be implemented into any microbiology laboratory.
-
BACT/ALERT® 3D
The Method of Choice for Rapid Sterility Testing
BACT/ALERT® 3D was developed as an effective and safe solution for industrial sterility testing. From its ease of use to its flexibility, BACT/ALERT® 3D is a state-of-the art microbial detection system suitable for any size laboratory, providing you with a reliable and objective alternative to traditional microbial detection methods.
-
BACT/ALERT® VIRTUO®
The Next Dimension in Platelet Quality Control
The BACT/ALERT® VIRTUO® is the new standard in platelet culture detection systems—a fully automated solution with quicker time to detection and minimal hands on time.
-
BIOBALL® Standardized Strains
Take Control of Your Microbiological QC
BIOBALL® is a small water-soluble ball containing a precise number of microorganisms that delivers accuracy and precision, batch after batch.
-
BIOBALL® Custom Services
BIOBALL® Custom Services helps you simplify the implementation of microbial strains of your interest in the routine microbiological quality control.
-
BIOFIRE® Mycoplasma
1-Hour Mycoplasma Testing by Anyone, Anywhere, Anytime
BIOFIRE® Mycoplasma provides simple, accurate, and rapid in-house mycoplasma detection for use in testing raw materials, in-process samples, and final product release. We offer validation services designed to meet regulatory requirements—from documentation to comprehensive on-site support.














?qlt=85&ts=1730190298905&dpr=off)

?qlt=85&wid=1024&dpr=off&ts=1765360628365)
